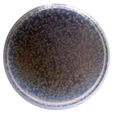
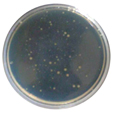

- HOME >
- 제품소개 >
- ANYPOLⅡ

ANYPOLⅡ는 항균물질을 KS J 4206 시험방법에 의거하여 테스트한 결과 기존 EPS 대비 우수한 항곰팡이 및 항균특성을 나타냅니다.
ANYPOLⅡ 항곰팡이 및 항균 특성 Test결과
| 구분 | 곰팡이 감소율(%) | 균주 감소율(%) | |||
|---|---|---|---|---|---|
| 곰팡이균AspergillusnigerATCC 16404 | 황색포도상구균Staphylococcusaureus ATCC 6538 | 대장균Escherichia coliATCC 25922 | 녹농균Pseudomonasaeruginosa ATCC 27853 | 효모균Candida albicansATCC 10231 | |
| EPS | 22.5 | 29.8 | 24.2 | 26.8 | 27.8 |
| ANYPOLⅡ | 99.9 | 99.9 | 99.9 | 99.9 | 99.9 |
항곰팡이 및 항균력 Test 결과 표본
| 구분 | 곰팡이 | 항균력 | |
|---|---|---|---|
| 곰팡이균AspergillusnigerATCC 16404 | 녹농균Pseudomonasaeruginosa ATCC 27853 | 효모균Candida albicansATCC 10231 | |
| EPS | ![]() |
![]() |
![]() |
| ANYPOLⅡ | ![]() |
![]() |
![]() |